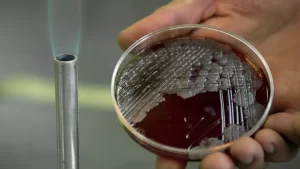
1022388628 0 60 2000 1185 1280x0 80 0 0 e546a267cb430d6976b213fba6e161cc.jpg

دراسة: بكتيريا الأمعاء مرتبطة بمرض السكري
أظهرت دراسة مستمرة في مركز”سيدرز سيناي”، أن بعض بكتيريا الأمعاء قد تزيد من خطر الإصابة بمرض السكري من النوع 2، وبينما قد يوفر نوع آخر من البكتيريا الحماية ضد هذا المرض. ووفقا للدراسة التي نشرت في مجلة “مرض السكري”، ترتبط المستويات الأعلى من بكتيريا “كوبروكوكوس” بتحسين حساسية الأنسولين، بينما ترتبط المستويات الأعلى من “فلافونيفراكتور” في ميكروبيوم الأمعاء بانخفاض حساسية الأنسولين.







